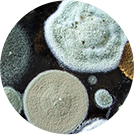

Αλλεργία σε σκόνη και ακάρεα σκόνης
Παρόλο που δεν φαίνονται με γυμνό μάτι, τα ακάρεα της σκόνης ζουν ανάμεσά μας. Πρόκειται για μικροσκοπικά έντομα που μοιάζουν με αράχνες και βρίσκονται σε όλο το σπίτι, προσκολλούνται σε υφάσματα, ταπετσαρίες, κλινοσκεπάσματα, μαξιλάρια και στρώματα. Τα ακάρεα σκόνης αποτελούν τη συνηθέστερη αιτία αλλεργιών εσωτερικών χώρων.
Αυτά τα έντομα, αόρατα με γυμνό μάτι, ζουν αποκλειστικά σε εσωτερικούς χώρους. Τρέφονται με τα εκατομμύρια νεκρά δερματικά κύτταρα που αποβάλλουμε καθημερινά από το σώμα μας. Η οικιακή σκόνη συντίθεται από πολλά σωματίδια – ίνες υφασμάτων, βακτήρια και ακάρεα σκόνης.
Όπως συμβαίνει με όλους τους παράγοντες που πυροδοτούν αλλεργίες, εάν γνωρίζετε ότι είναι η αιτία των συμπτωμάτων σας θα μπορέσετε να εφαρμόσετε ανάλογες στρατηγικές για την αντιμετώπισή τους.
Αλλεργία στη μούχλα
Παρά το γεγονός ότι συνήθως συνδέουμε τα συμπτώματα της αλλεργικής ρινίτιδας με τα φυτά και τη γύρη, οι σπόροι που απελευθερώνονται από τη μούχλα μπορεί συχνά να είναι ένας κρυφός εχθρός, ο οποίος προκαλεί συμπτώματα παρόμοια με αυτά της αλλεργικής ρινίτιδας. Η μούχλα είναι ένα κοινό αλλεργιογόνο που βρίσκεται σε φυσικούς εξωτερικούς χώρους, αλλά μπορεί επίσης να εμφανιστεί σε υγρά περιβάλλοντα του σπιτιού σας. Η ανάπτυξη της μούχλας συνήθως κορυφώνεται στα τέλη του καλοκαιριού και διαρκεί έως το φθινόπωρο, ανάλογα με την υγρασία που επικρατεί σε κάθε περιοχή.
Οι μικροσκοπικοί και αερομεταφερόμενοι σπόροι της μούχλας που προκαλούν αλλεργικές αντιδράσεις υπάρχουν σε εσωτερικούς αλλά και εξωτερικούς χώρους και αναπτύσσονται αμφότερα τα περιβάλλοντα, εφόσον υπάρχουν οι κατάλληλες συνθήκες, δηλαδή υγρασία και σκοτάδι. Εάν γνωρίζετε ότι υποφέρετε από αλλεργία στην εσωτερική μούχλα, έχετε κάνει ήδη το πρώτο βήμα για την αντιμετώπισή της. Εξαλείφοντας την πηγή της μούχλας μπορεί να επιλύσετε πλήρως το πρόβλημα.
Για να μάθετε περισσότερες πληροφορίες σχετικά με την αντιμετώπιση των αλλεργιών, κάντε κλικ εδώ. Εάν αναζητάτε πιο αναλυτικές συμβουλές για την αντιμετώπιση των αλλεργιών εσωτερικών χώρων, κάντε κλικ εδώ.

Αντιισταμινικά
Βρείτε ποια είναι η κατάλληλη λύση για εσάς.

Αναζητάτε ανακούφιση από τα συμπτώματα αλλεργίας;
Μάθετε πώς η τοπική χρήση αντιισταμινικών μπορεί να βοηθήσει στην αποτελεσματική αντιμετώπιση των αλλεργιών όλο το χρόνο.
